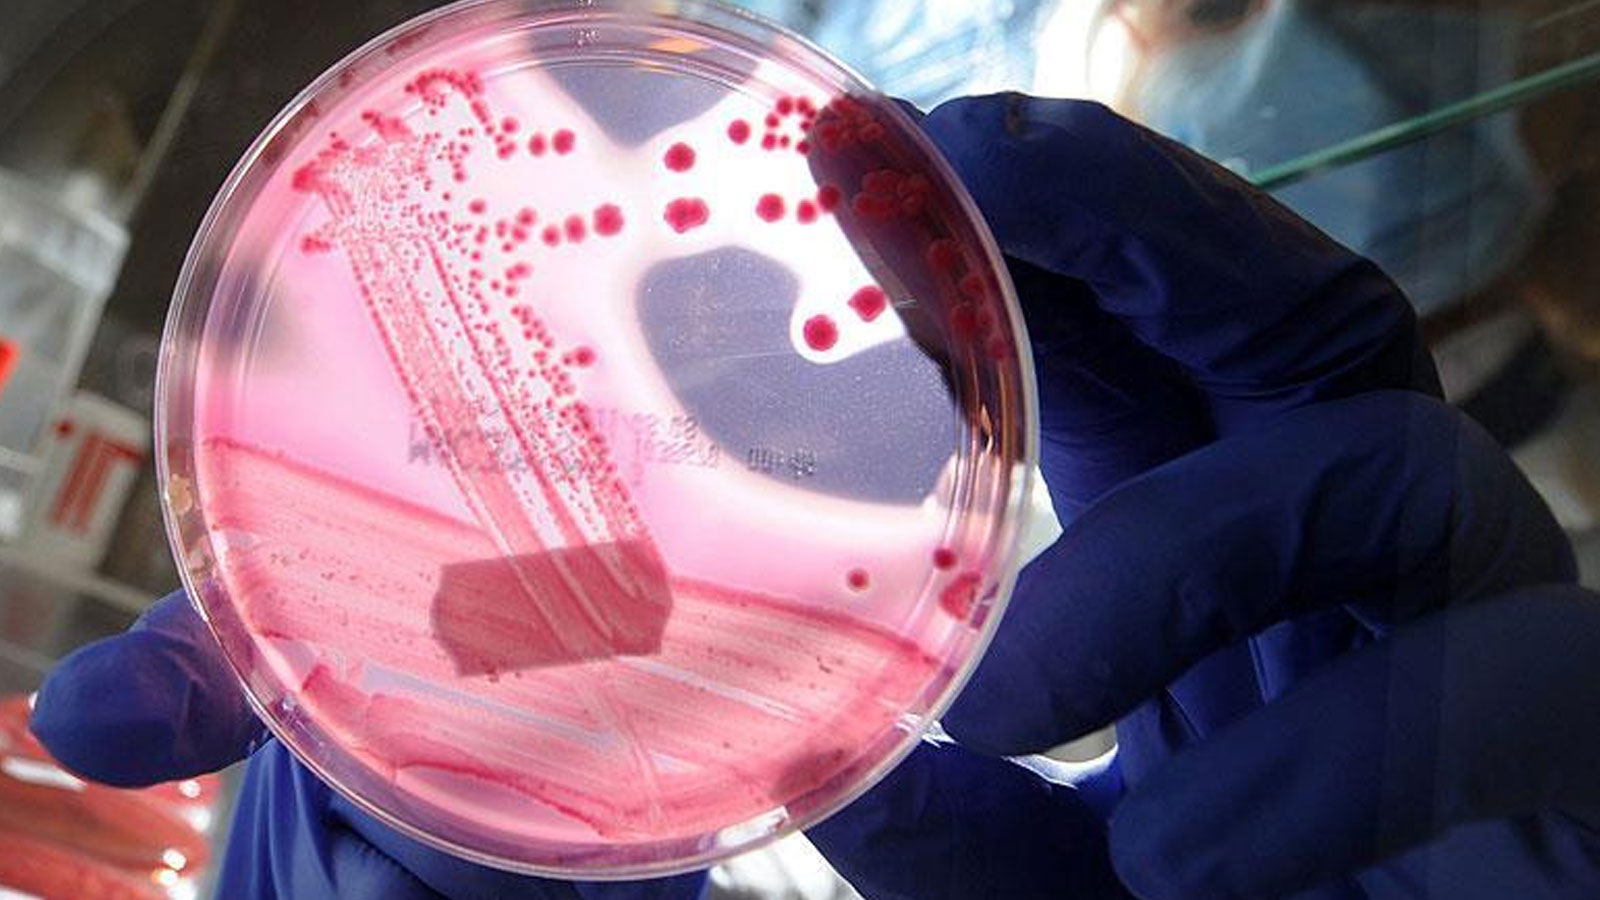
Découverte naturelle qui peut arrêter le cancer des scientifiques

Les scientifiques ont découvert un composé naturel qui peut arrêter la progression de certains types de cancer et de cellules nerveuses telles que la sclérose en plaques (MS). Cette étude menée par l’Oregon Health and Science University (OHSU) a été possible grâce à des années de travail d’étudiants à l’Université de Portland.
Dans les examens, un composé flavonoïde appelé sulfurétine trouvé dans les plantes a neutralisé une enzyme importante associée au cancer et à la SEP.
Les scientifiques ont observé que la sulfurétine a arrêté l’activité de cette enzyme dans leurs expériences dans l’environnement de laboratoire. Maintenant, il est prévu d’examiner l’effet thérapeutique, la sécurité et les effets secondaires possibles de cette substance sur les animaux.
Découverte d’espoir contre les maladies
Larry Sherman, l’un des professeurs menant la recherche, pense que ce composé découvert peut être utilisé dans le traitement de nombreuses maladies différentes. La sulfurétine, une hyaluronidase appelée enzyme s’est avérée empêcher le fonctionnement. Cette enzyme peut désintégrer l’acide hyaluronique dans le corps et provoquer certaines maladies.
La désintégration de l’acide hyaluronique peut retarder la réparation de la gaine de myéline qui protège les cellules nerveuses. Ceci est associé à la SEP, à la paralysie, aux lésions cérébrales et à certains types de démence. Cela peut également entraîner une prolifération incontrôlée des cellules cancéreuses. Les scientifiques pensent que la sulfurétine a le potentiel d’arrêter ce processus.
Guérison des plantes
Cette découverte importante est apparue à la suite de nombreuses années de recherche à l’Université de Portland. Le professeur de chimie, Angela Hoffman et ses étudiants, ont examiné les différents composés qu’ils ont obtenus des plantes un par un et ont tenté de déterminer les plus efficaces contre les maladies. À la suite de ces années d’études, la sulfurétine a été l’un des composés les plus prometteurs.
Les scientifiques qui contribuent à cette recherche pensent que la sulfurétine peut bénéficier non seulement dans le cancer et la SEP, mais aussi dans d’autres maladies neurodégénératives telles qu’Alzheimer. Maintenant, les effets de ce composé sur la santé humaine seront étudiés plus en détail.